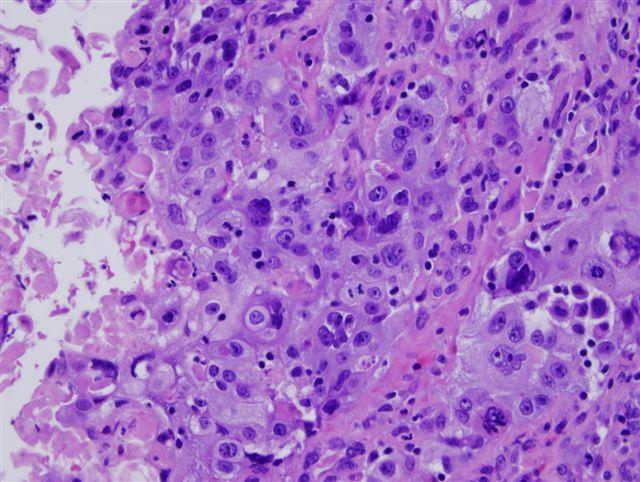

Симптомы и признаки
Рак шейки матки, особенно плоскоклеточный, является серьезным заболеванием. Он развивается медленно, что затрудняет раннюю диагностику. Если не обратить внимание на поражение органа, борьба с недугом станет сложнее.
Предраковое состояние может длиться годами, и в этот период пациент может не ощущать недомоганий, считая себя здоровым. Поэтому важно заботиться о своем здоровье, пока вероятность благоприятного исхода еще высока.
Особое внимание стоит уделить женщинам в возрасте от 21 до 25 лет или тем, кто начал сексуальную жизнь более трех лет назад. Рекомендуется пройти лабораторные исследования на наличие ВПЧ-16, ВПЧ-18 и других вирусов, повышающих риск онкологии.
Если в анамнезе есть несколько неблагоприятных факторов, следует насторожиться. Эти маркеры могут указывать на риск развития рака:
- Инфекционные заболевания.
- Хронический герпес, гепатиты В и С, инфекции, передающиеся половым путем.
- Периодические изменения или нарушения вагинальной флоры.
- Недостаток витаминов А и С, нехватка бета-каротина, пониженный уровень иммунитета, употребление наркотиков, алкоголь и курение.
- Длительное использование оральных контрацептивов (более пяти лет), сбои в гормональном фоне, ранний или поздний климакс.
- Большое количество беременностей (более четырех).
Вирус папилломы человека также является фактором риска онкологии. Он может проявляться следующими симптомами:
- Бородавки, одиночные или множественные, сероватого или розового цвета, напоминающие цветную капусту или петушиный гребешок. Эти признаки могут сочетаться с заболеваниями иммунной системы и диабетом.
- Локализация в области влагалища, промежности и половых губ, а также на стенках шейки матки.
Как выглядят раковые клетки при проведении цитологии шейки матки
Раковые клетки отличаются от нормальных по нескольким признакам:
- Полиморфизм. В мазке можно увидеть клетки одной ткани, но с различными размерами, формами и структурой.
- Анизоцитоз. Наблюдается изменение размера клеток — как уменьшение, так и увеличение.
- Анизокариоз. Ядра клеток могут быть как увеличенными, так и уменьшенными. Ядро — центральный элемент клетки, содержащий генетический материал и необходимый для деления.
- Изменение формы и количества ядер. Ядра раковых клеток могут быть неправильной формы, бесформенными и с неровными контурами. Встречаются двухъядерные и многоядерные клетки, а иногда можно увидеть только ядра без других клеточных элементов.
- Изменения в цитоплазме. При окрашивании цитоплазма имеет неравномерную окраску.
Цитологическое исследование
Раковые опухоли характеризуются усиленным ростом, поэтому в образце, взятом для цитологии шейки матки, обнаруживаются делящиеся клетки. Часто деление происходит с нарушениями, что называется атипичным митозом.
Чем менее зрелые клеточные структуры находятся в мазке, тем ниже дифференцировка опухоли. Этот показатель обозначается буквой G, а рядом стоит цифра, указывающая на степень дифференцировки. Чем выше цифра, тем злокачественнее рак.
Клиника и лечение плоскоклеточного рака шейки матки
В преинвазивной (нулевой) и микроинвазивной стадиях рака, протекающих бессимптомно, в 49% случаев обычное пальпаторное обследование и визуальный осмотр не выявляют характерных изменений. Однако морфофункциональные изменения злокачественного характера можно обнаружить с помощью кольпоскопии и цитологических исследований.
Наиболее ранние клинические симптомы включают обильные водянистые выделения и кровотечения. При присоединении бактериальной инфекции выделения становятся мутными и приобретают неприятный запах. Этот симптом наблюдается в среднем у 1/3 больных, но не является специфичным, так как может сопровождать воспалительные процессы во влагалище и яичниках. Постепенное увеличение выделений, их грязноватый или сукровичный характер вызывает настороженность в отношении возможного злокачественного образования.
Характерные признаки включают «контактные» кровянистые выделения после полового акта, физической нагрузки или инструментального гинекологического осмотра. В репродуктивном периоде могут наблюдаться ациклические кровотечения, а в климактерическом — беспорядочные и длительные. Эти кровотечения часто ошибочно воспринимаются как нарушения менструального цикла. В период менопаузы из-за повышенной ломкости сосудов эта симптоматика может проявляться очень рано.
При прогрессировании рака шейки матки на более поздних стадиях (IIB и далее) могут появляться боли в поясничной области, крестце, нижних конечностях и нижних отделах живота, а также дизурические явления, запоры и частые позывы на акт дефекации.
Читайте больше о заболевании в статье «Рак шейки матки».
Общие принципы терапии
Принципы лечения основаны на индивидуальном подходе и сочетании радикальности терапии с сохранением органа и его функций (менструальной, репродуктивной). Для этого применяются хирургические, лучевые, химиотерапевтические и комбинированные методы. Выбор методов и объем хирургического вмешательства зависит от локализации и размеров опухоли, стадии заболевания и индивидуальных особенностей пациента.
Среди хирургических методов используются конизация с выскабливанием, экстирпация или расширенная модифицированная экстирпация матки, а также удаление лимфоузлов. Эти методы могут сочетаться с лучевой и адъювантной химиотерапией.
При ранней диагностике заболевание поддается успешному лечению. Прогноз пятилетней выживаемости при плоскоклеточном раке шейки матки составляет 100% на нулевой и преинвазивной стадиях, 96,7% на стадии IA, в среднем 92,8% на стадии IB, 58-63% на стадии II, 33% на стадии III и менее 15% на стадии IV.
Ключевыми факторами для раннего выявления онкологических заболеваний и снижения заболеваемости раком являются скрининговые программы с использованием кольпоскопии, цитологии, гистологии, вирусологии, включая тестирование ДНК папилломавирусов и других вирусов.
Первые признаки и симптомы рака шейки матки
Гинеколог может заподозрить рак шейки матки или предраковое состояние во время стандартного осмотра, даже если симптомы еще не проявились. Это заболевание легко диагностировать, если регулярно посещать врача; в противном случае опухоль может быть выявлена слишком поздно.
Рак шейки матки коварен тем, что явные признаки появляются на поздних стадиях. Долгое время женщина не подозревает о болезни и не ощущает тревожных симптомов.
Первые признаки рака возникают поздно и связаны с особенностями роста опухоли, которая окружена сетью кровеносных сосудов, легко травмирующихся. Это может привести к спонтанным кровотечениям после физических нагрузок или полового акта. Стандартный гинекологический осмотр также может вызвать кровянистые выделения.
На второй стадии рака шейки матки наблюдаются следующие симптомы:
- контактные кровотечения;
- слабость и утомляемость;
- длительные менструации;
- дискомфорт в области малого таза.
На этой стадии выраженные боли отсутствуют. Они появляются позже, когда опухоль затрагивает нервы и проникает в область малого таза, вызывая ноющие боли, которые могут иррадиировать в поясницу. Боли могут возникать во время секса или без видимой причины.
Сдавление мочеточника опухолью приводит к нарушению оттока мочи и появлению крови в урине. Полное перекрытие мочеточника и поражение мочевого пузыря могут вызвать прекращение мочеиспускания, что ведет к отравлению организма.
На поздних стадиях поражение кишечника может вызвать запоры и кровь в моче. Если образуется вагинально-кишечный или вагинально-пузырный свищ, каловые массы или моча могут выделяться через влагалище.
Увеличение лимфоузлов в паху нарушает венозный отток, что проявляется отеками нижних конечностей и наружных половых органов. На поздних стадиях распад опухоли сопровождается зловонными выделениями, напоминающими мясные помои с гноем.
Раковая интоксикация вызывает повышение температуры, лихорадку, потерю веса, а повторяющиеся кровотечения могут привести к анемии и слабости.
Классификация опухолей шейки матки по МКБ-10
В международном классификаторе болезней МКБ-10 злокачественным и доброкачественным опухолям шейки матки присвоены следующие коды:
| Тип опухоли | Уточнение | Обозначение по МКБ-10 |
|---|---|---|
| Карцинома in situ | Общее обозначение | D06 |
| Внутренней части шейки | D06.0 | |
| Наружной части | D06.1 | |
| Других частей | D06.7 | |
| Неуточненная | D06.9 | |
| Злокачественное новообразование | Общее обозначение | C53 |
| Внутренней части шейки | C53.0 | |
| Наружной части | C53.1 | |
| Выходящее за пределы одной области | C53.8 | |
| Неуточненное | C53.9 | |
| Миома (леомиома) | Общее обозначение | D25.0 |
| Неуточненная | D25.9 | |
| Полипы шейки матки | N84.1 | |
| Эмбриональная киста | Q51.6 | |
| Другие доброкачественные новообразования | D26.0 |
Методы лечения
Терапия плоскоклеточной карциномы шейки матки подбирается индивидуально и зависит от нескольких факторов:
- Тип опухоли и степень инвазии;
- Стадия заболевания;
- Наличие сопутствующих патологий;
- Возраст пациентки.
Онкологи обычно комбинируют различные терапевтические методы для повышения прогноза после лечения.
Хирургическое вмешательство
Операция будет эффективной, если плоскоклеточная карцинома имеет неороговевающий тип и диагностирована на ранних стадиях. В некоторых случаях врач дополняет хирургическое вмешательство облучением. Неинвазивные и микроинвазивные формы онкопатологии лечатся конизацией шейки матки, при которой удаляется пораженный участок в форме конуса. Удаление может осуществляться скальпелем, электрокоагуляцией, лазером или радиоволнами.
Лучевая терапия
Облучение уничтожает злокачественные клетки, что способствует уменьшению новообразования. Радиотерапия бывает внутриполостной и дистанционной. Врачи часто комбинируют эти методы. Лечение может проводиться до операции для уменьшения объема вмешательства или после, чтобы уничтожить остаточные злокачественные клетки.
В некоторых случаях лучевая терапия вызывает атрофию слизистой влагалища и прекращение функции яичников, но это значительно безопаснее, чем плоскоклеточный рак.
Химиотерапия
Химические препараты при плоскоклеточной онкологии шейки матки не используются как основной метод терапии. Химиотерапия и облучение могут проводиться до и после операции. Перед началом лечения пациентку подготавливают, назначая травяные сборы для снижения выраженности побочных эффектов.
Чаще всего требуется полиохимиотерапия, которая включает несколько препаратов. Лечение проходит в несколько курсов с интервалами от нескольких недель до нескольких месяцев, в зависимости от реакции организма. На четвертой стадии заболевания химиотерапия назначается как паллиативное лечение.
Виды
Онкологическое заболевание имеет две формы:
-
Плоскоклеточный неороговевающий рак матки. Это овальная или многогранная опухоль с зернистой цитоплазмой. Частота проявления составляет 65%. Эта форма считается промежуточной, так как клетки способны значительно изменять свои размеры и форму.
-
Плоскоклеточный ороговевающий рак матки. Наблюдается в 20% случаев. Отличается наличием ороговевших очагов, известных как «раковые жемчужины», которые хорошо видны под микроскопом. Это облегчает раннюю диагностику, а лечение имеет более благоприятный прогноз. Характерные свойства ороговевшей опухоли включают активный рост измененных клеток и их быстрое распространение по организму.
В зависимости от степени структурных и функциональных изменений клеток и скорости их развития различают несколько типов плоскоклеточного рака шейки матки.
Высокодифференцированный
Неороговевающая опухоль с высокой дифференцировкой считается излечимой, так как не образует метастазов. В большинстве случаев лечение направлено на сохранение функций детородных органов.
Низкодифференцированный
Такая патология отличается высокой агрессивностью. Низкодифференцированная опухоль быстро развивается, разрушая окружающие ткани.
Клетки новообразования с низкой степенью дифференцировки значительно изменяются. Часто основная причина этих изменений остается неясной. Онкологическое поражение данного типа диагностируется в 15% случаев.
Умеренно дифференцированный
Плоскоклеточный рак матки со средним уровнем дифференцировки клеток — более распространенная патология. Его симптомы обычно выражены, а прогноз при раннем выявлении часто благоприятный.
Инвазивный плоскоклеточный рак шейки матки
При данной форме ракового образования наблюдается развитие злокачественных клеток, которые метастазируют за пределы матки.
Инвазивный плоскоклеточный рак шейки матки
Из всех плоскоклеточных опухолей, поражающих шейку матки, инвазивные новообразования встречаются у 60% пациентов, преимущественно у женщин старше пятидесяти лет.
Классификация и стадии развития рака шейки матки
Гистологически выделяют следующие типы рака шейки матки:
- Плоскоклеточный рак — возникает из клеток эпителия цервикального канала и экзоцервикса, составляет 70-80 % всех случаев.
- Аденокарцинома (железистый рак) — возникает из эпителия желез шейки матки, составляет 10-20 % случаев.
- Низкодифференцированный рак — 10 % случаев.
- Другие гистологические типы злокачественных опухолей — менее 1 % (включая стекловидноклеточный рак, нейроэндокринные опухоли, аденобазальный рак и др.).
Для рака шейки матки разработана классификация TMN, которая определяет распространённость опухолевого процесса. Выделяют клиническую и патоморфологическую стадии. Клиническую стадию устанавливают до начала лечения на основе осмотра, пальпации, кольпоскопии, биопсии, выскабливания, урографии, цистоскопии, ректороманоскопии, компьютерной томографии и УЗИ. От клинического стадирования зависит тактика лечения. Патоморфологическое стадирование проводят после операции на основе гистологического исследования, что позволяет более точно определить дальнейшую тактику лечения и прогноз.
В клинической практике также используется классификация FIGO. Ниже приведены стадии рака шейки матки (по FIGO, 2009 г.) и распространённость опухолевого процесса (TMN, 2010 г.):
- Тх — недостаточно данных для оценки распространённости опухоли.
- Tis — рак на месте, опухоль не проникает через базальную мембрану; многие специалисты приравнивают к этой стадии дисплазию шейки матки тяжёлой степени (CIN III). По FIGO — стадия 0.
- Т1 — опухоль ограничена шейкой матки. Стадия по FIGO 1.
- Т1а — инвазивная опухоль, не визуализируется, определяется только при гистологическом исследовании. Стадия по FIGO 1а.
- Т1а1 — инвазия в строму шейки не превышает 3 мм в глубину и 7 мм в ширину. Стадия по FIGO 1а1.
- Т1а2 — инвазия в строму шейки от 3 до 5 мм, горизонтальное распространение не более 7 мм. Стадия по FIGO 1а2.
- T1b — клинически определяемое поражение, глубина инвазии более 5 мм или горизонтальное распространение более 7 мм. Стадия по FIGO 1b.
- T1b1 — опухоль менее 4 см. Стадия по FIGO 1b1.
- T1b2 — опухоль более 4 см. Стадия по FIGO 1b2.
- Т2 — опухоль выходит за пределы шейки матки, но не вовлекает параметрий. Стадия по FIGO 2.
- T2a — опухоль менее 4 см. Стадия по FIGO 2a.
- T2b — опухоль более 4 см. Стадия по FIGO 2b.
- Т3 — опухоль выходит за пределы шейки матки с вовлечением стенок малого таза и нижней трети влагалища, возможен гидронефроз. Стадия по FIGO 3.
- Т3а — опухоль поражает нижнюю треть влагалища. Стадия по FIGO 3a.
- T3b — опухоль поражает стенку таза и/или приводит к гидронефрозу и нефункционирующей почке. Стадия по FIGO 3b.
- Т4 — опухоль прорастает в мочевой пузырь и прямую кишку. Стадия по FIGO 4а.
- MX — недостаточно данных для оценки наличия отдалённых метастазов.
- M1 — наличие отдалённых метастазов. Стадия по FIGO 4b.
- NX — недостаточно данных для оценки распространённости опухолевого процесса в лимфатической системе.
- N0 — нет признаков вовлечения регионарных лимфатических узлов.
- N1 — метастазы в регионарных лимфатических узлах.
Как выглядит плоскоклеточный рак?
Внешние характеристики плоскоклеточного рака
| Вид рака | Форма роста | Описание | Фото |
|---|---|---|---|
| Плоскоклеточный рак кожи | Инфильтративно-язвенная | Плотный язвенный дефект кожи с четкими краями. Поверхность покрыта желтоватой корочкой из роговых масс. При удалении корочки открывается неровное, кровоточащее дно язвы. Близлежащая кожа воспалена, красная и отечная. | |
| Опухолевая | Возвышающееся опухолевидное образование на широком основании. На поверхности видны мелкие кровеносные сосуды. В центре — небольшое углубление темно-коричневого цвета, заполненное желтоватыми роговыми массами. | ||
| Плоскоклеточный рак красной каймы губ | Инфильтративно-язвенная | Неправильной формы язвенный дефект красной каймы губ с четкими, слегка подрытыми краями. Дно бугристое, покрыто черными участками некроза и желтыми роговыми массами. | |
| Опухолевая | Плотный узел на широком основании, переходящем на слизистую губ и кожу лица. Поверхность покрыта роговыми корками. В центре — очаг некроза черного цвета. Кожа вокруг деформирована, воспалена и отечна. | ||
| Плоскоклеточный рак полости рта | Инфильтративная | Ярко-красная слизистая оболочка с бугристой поверхностью и неровными краями. Местами — желтые корки, удаление которых вызывает кровоточивость. | |
| Опухолевая | Узловое образование с четкими, неровными краями. Поверхность бугристая, шероховатая, обильно покрыта роговыми массами. Окружающая слизистая оболочка не изменена. | ||
| Плоскоклеточный рак пищевода | Инфильтративно-язвенная | При эндоскопии выявляется язвенный дефект слизистой оболочки пищевода с четкими границами. Края приподняты, поверхность бугристая, слегка выступает в просвет и легко кровоточит при контакте. | |
| Опухолевая | Множественные опухолевые образования различных размеров, выступающие в просвет пищевода. Основание широкое, продолжается слизистой оболочкой. Поверхность покрыта множеством кровеносных сосудов. | ||
| Плоскоклеточный рак гортани | Смешанная | Объемное образование неправильной формы с неровной поверхностью, на которой видны желтые корки и точечные кровоизлияния. Слизистая на поверхности опухоли и вокруг нее изъязвлена. | |
| Плоскоклеточный рак трахеи и бронхов | Опухолевая | При эндоскопии определяются бугристые выросты конусовидной формы, выступающие в просвет дыхательных путей. Поверхность покрыта белым налетом, изъязвлена и местами кровоточит. | |
| Плоскоклеточный рак шейки матки | Инфильтративно-язвенная | При гинекологическом обследовании видна покрасневшая, изъязвленная, кровоточащая шейка матки с четкими, слегка приподнятыми краями язвы. В некоторых местах — желтые корочки. | |
| Опухолевая | Объемное образование на широком основании, выступающее над поверхностью слизистой оболочки шейки матки. Поверхность бугристая, шероховатая, местами изъязвленная и кровоточащая. |
Причины развития
Раковое поражение шейки матки (ШМ) занимает шестое место по распространенности среди онкологических заболеваний, уступая карциномам груди, желудочно-кишечного тракта и матки. Онкологи чаще всего сталкиваются с плоскоклеточной формой карциномы. У женщин с раком шейки матки этот тип опухоли диагностируется в 95% случаев. Регулярные плановые осмотры на гинекологическом кресле помогают предотвратить плоскоклеточную опухоль, так как ей предшествуют процессы, которые успешно поддаются терапии.
Основной причиной развития плоскоклеточного рака ШМ врачи считают вирус папилломы человека (ВПЧ), особенно подтипы 16 и 18. Этот вирус также может вызывать цервикальную интраэпителиальную неоплазию (дисплазию шейки матки). К предраковым состояниям относятся эрозии, полипы, гормональные сбои и эктопии.
Другими факторами риска плоскоклеточной карциномы ШМ являются хламидиоз, цитомегаловирус и второй тип герпетического вируса.
Дополнительные факторы, способствующие развитию заболевания:
- раннее начало половых контактов (до 17 лет);
- роды до 18 лет;
- большое количество половых партнеров или их частая смена;
- аморальный образ жизни;
- воспалительные заболевания половой системы;
- наличие внутриматочной спирали (ВМС);
- травмы шейки матки во время родов, искусственного прерывания беременности, выскабливания, неоднократной конизации или прижигания эрозии.
В пожилом возрасте опухоль шейки может развиваться из-за дегенеративных изменений слизистой. Генетическая предрасположенность также играет важную роль в формировании новообразования.
Симптомы
Симптомы
- Экзофитная форма (папиллярная) проявляется в виде четко отграниченного узелка, который постепенно увеличивается. Опухоль напоминает соцветия цветной капусты и имеет красно-коричневый цвет. Ее поверхность неровная и бугристая, с выраженной впадиной в центре. Она может крепиться к слизистой или коже на тонкой ножке или широком основании. Со временем поверхность экзофитной опухоли может изъязвляться, что указывает на переход в эндофитную форму.
- Эндофитная форма (инфильтративно-язвенная) характеризуется быстрым изъязвлением небольшого первичного узелка, в результате чего образуется большая язва неправильной формы. У язвы плотные, приподнятые края и шероховатое дно, покрытое белесым налетом с неприятным запахом. Она практически не увеличивается в размерах, так как опухоль проникает вглубь тканей, затрагивая мышцы, кости и соседние органы.
- Смешанная форма.
Плоскоклеточный рак кожи
Опухоль имеет следующие признаки:
- Болезненность;
- Отек окружающих тканей;
- Зуд;
- Ощущение жжения;
- Покраснение кожи вокруг опухоли;
- Кровоточивость с поверхности опухоли.
Плоскоклеточный рак легкого
- Сухой кашель, не поддающийся лечению противокашлевыми средствами и продолжающийся длительное время;
- Кашель с кровью или слизью;
- Частые заболевания легких;
- Боль в грудной клетке при вдохе;
- Необъяснимое похудение;
- Хриплый голос;
- Постоянно повышенная температура тела.
Плоскоклеточный рак матки
- Боли в животе (локализуются в нижней части и могут иррадиировать в другие области);
- Бели;
- Кровотечение;
- Повышенная утомляемость;
- Общая слабость.
Плоскоклеточный рак шейки матки
- Вагинальные кровотечения, чаще всего после полового акта;
- Боль во время полового акта;
- Постоянные ноющие боли в нижней части живота;
- Проблемы с мочеиспусканием и дефекацией.
Подробнее о раке шейки матки.
Плоскоклеточный рак вульвы
- Раздражение и зуд в области наружных половых органов, усиливающиеся ночью. Зуд проявляется приступами.
- Изъязвление наружных половых органов.
- Мокнутие в области входа в половую щель.
- Боль и уплотнение тканей в области наружных половых органов.
- Гнойные или кровянистые выделения из половой щели.
- Отек вульвы, лобка и ног (характерно для поздних стадий и запущенных случаев).
бородавки, ссадины
Плоскоклеточный рак гортани
- Трудности с дыханием (как при вдохе, так и при выдохе);
- Хрипота или полная потеря голоса из-за повреждения голосовых связок;
- Боль при глотании;
- Упорный сухой кашель, не поддающийся лечению противокашлевыми средствами;
- Кровохарканье;
- Ощущение инородного тела в горле.
Плоскоклеточный рак пищевода
- Трудности с глотанием: сначала сложно проглатывать твердую пищу, затем мягкую, а в конце — и воду;
- Боль в груди;
- Срыгивание кусочками пищи;
- Неприятный запах изо рта;
- Кровотечение, проявляющееся в рвоте или стуле с кровью.
Плоскоклеточный рак языка, горла и щеки
- Боли, распространяющиеся на окружающие ткани и органы;
- Усиленное слюноотделение;
- Неприятный запах изо рта;
- Затруднения при жевании и речи.
Плоскоклеточный рак прямой кишки
- Нарушения стула: чередование поносов и запоров;
- Ощущение неполного опорожнения кишечника после дефекации;
- Ложные позывы к дефекации;
- Ленточный кал (кал в виде тонкой ленты);
- Примесь крови, слизи или гноя в кале;
- Болезненность при дефекации;
- Недержание кала и газов (характерно для поздних стадий);
- Боли в животе и области ануса;
- Общая слабость, бледность, анемия и потеря веса на поздних стадиях;
- Недержание мочи.
Плоскоклеточный рак желудка
- Постоянный дискомфорт и тяжесть в желудке, усиливающиеся после еды.
- Постоянные боли в области желудка.
- Нарушение аппетита, вплоть до отвращения к пище, особенно к мясным продуктам.
- Быстрое насыщение.
- Тошнота и рвота.
- Рвота «кофейной гущей» или с частичками крови.
- Отрыжка.
- Черный кал (мелена).
- Затруднение глотания, слюнотечение и боли за грудиной при раке в области перехода пищевода в желудок.
- Упорная рвота и тяжесть в желудке при раке в области перехода желудка в двенадцатиперстную кишку.
- Анемия, снижение веса, общая слабость и низкая работоспособность на последних стадиях заболевания.
Диагностика
Своевременная диагностика раковых опухолей имеет особое значение. При первых признаках заболевания не следует откладывать визит к врачу.
Диагностика рака матки включает комплексное обследование. Сначала собирается анамнез, затем проводится визуальный и ручной осмотр пораженной области.
На следующих этапах диагностики выполняются различные исследования:
- тест Шиллера — определение патологии с помощью окрашивания влагалища йодсодержащими веществами;
- кольпоскопия;
- ультразвуковое исследование;
- цитологические мазки;
- биопсия;
- компьютерная томография;
- цистоскопия;
- рентгеноконтрастное исследование влагалища.
Обследование проводится только в специализированных медицинских центрах.
Цитологическое исследование мазка помогает уточнить диагноз.
Формы
Лечебные мероприятия и прогнозы зависят от формы плоскоклеточного рака шейки матки, который может быть ороговевающим или неороговевающим.
По этой классификации врачи определяют зрелость клеток карциномы:
-
Ороговевающий плоскоклеточный рак. Клеточные комплексы опухоли напоминают плоский эпителий. Такие новообразования растут медленно, в центре опухоли скапливается кератин, а вокруг располагаются недозрелые круглые клетки. Этот тип рака диагностируется в 25% случаев.
-
Неороговевающий плоскоклеточный рак. Встречается чаще. Гистологически клетки имеют различное строение, отличия в ядрах и степени зрелости. Эта форма рака прогрессирует быстрее и имеет менее благоприятный прогноз.
Также заболевание классифицируется по степени инвазии онкоклеток:
-
Преинвазивная форма. Лечение простое, так как это нулевая стадия. Новообразование является внутриэпителиальным и соответствует третьей степени цервикальной неоплазии. Риск метастазов отсутствует.
-
Микроинвазивный рак. Патологические элементы проникают в стромы на глубину до 0,5 см. Эта форма не агрессивна и переходит в следующую стадию не ранее чем через два года. Прогнозы очень высоки, риск метастазов невысок, окружающие органы и лимфатическая система функционируют нормально.
-
Инвазивный рак. Онкоклетки проникают в стромы на глубину более 3 мм. Опухоль начинает активно расти, лимфатическая система перестает выполнять свои функции. Риск метастазов значительно возрастает.
Степень дифференцировки клеток также важна для прогноза:
-
Низкодифференцированный рак. Встречается редко, имеет неблагоприятный прогноз. Рак агрессивен, быстро развивается и рано метастазирует. Злокачественные клетки сильно отличаются от здоровых.
-
Высокодифференцированный рак. Имеет хороший прогноз, растет медленно и не агрессивен. Клетки максимально похожи на здоровые и выполняют свои функции.
-
Умеренно дифференцированный рак. Встречается чаще всего. Опухоль прогрессирует со средней скоростью, метастазы образуются на завершающем этапе. Прогноз зависит от стадии на момент диагностики.
Степень инвазии определяется при кольпоскопии, а дифференцировка и ороговение — через гистологическое исследование биоматериала после биопсии.
Лечение опухолей шейки матки
Для лечения доброкачественных новообразований, таких как миомы, аденофибромы и аденомиомы небольших размеров, назначают комбинированные оральные контрацептивы для нормализации гормонального фона. Также могут использоваться другие препараты, подобранные индивидуально для каждой пациентки. Крупные образования подлежат удалению.
Оральные контрацептивы
Кисты и полипы удаляют с помощью лазера или радиоволнового метода. Эти методы не приводят к образованию рубцов и деформации тканей, что делает их подходящими для женщин, планирующих беременность и роды.
Злокачественные образования удаляются. При распространённых формах проводится удаление матки, поражённых лимфоузлов и яичников. В лечении онкологии применяются химио-, лучевая и гормональная терапия, часто в сочетании с операцией.
Профилактика включает своевременное обращение к врачу, регулярную сдачу анализов, прохождение УЗИ, а также лечение предраковых патологий и воспалительных процессов.
Эффективность лечения онкологии зависит от времени обращения. Заговорить опухоли или удалить их немедицинскими методами невозможно. Промедление усложняет лечение и ухудшает прогноз.